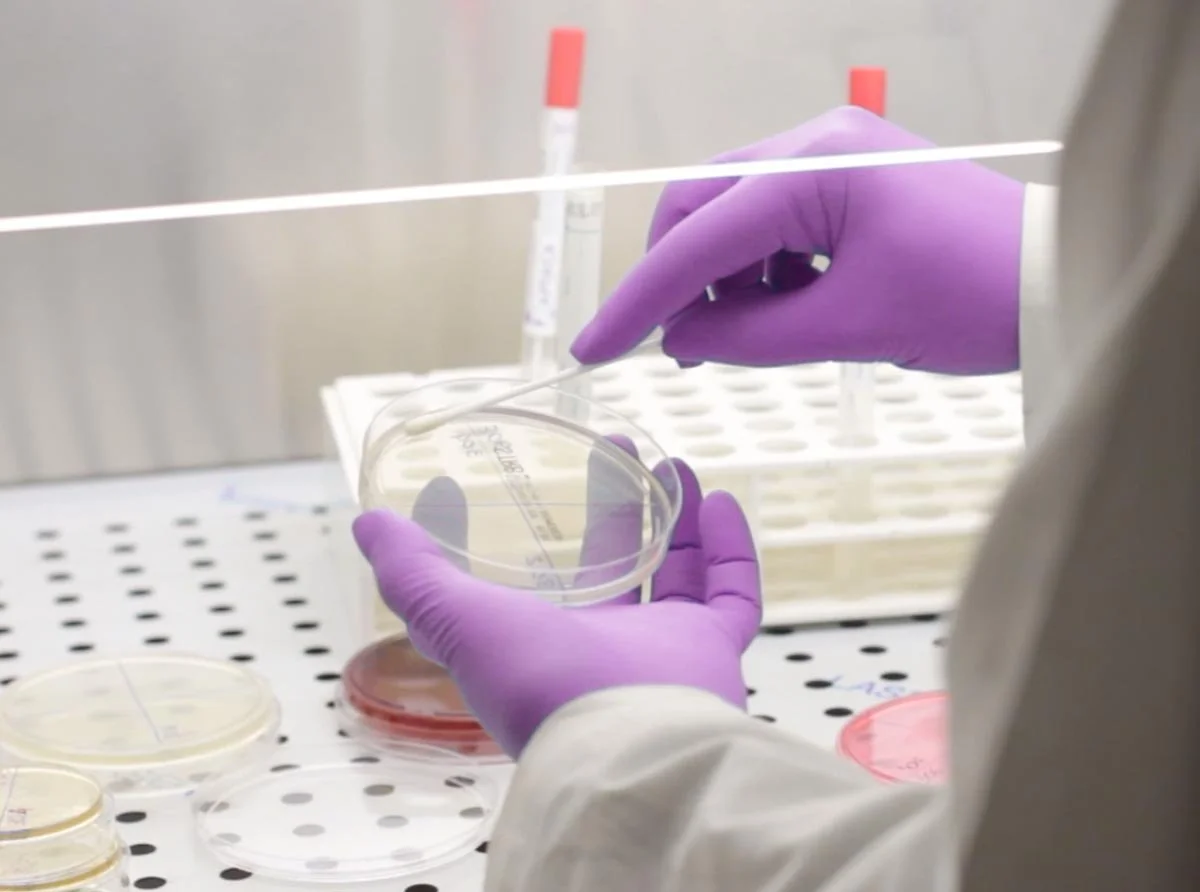

Rayguard & Svitec Scientific Resources
Scientific studies that prove the effectiveness of RayGuard products
RayGuard products have been on the market for over 25 years and are the result of continuous research. Products were provided with zusätzlichen improvements to satisfy even the ever larger size electric smog of 5G network and expanding to meet (1G 2G 3G 4G 5G).
The RayGuard for the harmonization of electrosmog and geopathogenic zones was tested with the following measuring methods, by which a positive effect on the well-being and the energy of the people could be proven.
Experiments on cell cultures, PROGNOS system analysis (skin resistance measurements over 24 meridian endpoints - 1984-1994 application in the MIR space station), electro-acupuncture measurement according to Dr. Voll (double-blind study), computer decoder dermography, heart rate variability measurements, bioelectronics according to Vincent, dark field microscopy, electrophysiological terminal point diagnosis, OET test (optical erythrocyte test), ROTS test (blood sedimentation test), REDOX analysis, holopathy (fifth system for holopathy ), Kirlian photography, Aschhoff blood test, kinesiology.
Biological Effects of Electromagnetic Radiation
The biological effects of electromagnetic radiation at 900 MHz are reduced when the RayGuard device is used. Experimental investigations on CCRF-CEM cell cultures. Institute for Normal and Pathological Cytomorphology CNR (Centro Nazionale di Ricerca) -Bologna.
Cell Study
The CNR Bologna institute carried out tests on the effect of electromagnetic waves (900 MHz - 5 V / m), such as those caused by cell phones and cell phone transmitters, on human CEM cells.
The results were:
1. The electromagnetic exposure showed a clear reduction in the cell growth rate and a change in the cell cycle, especially after 48 hours of exposure.
2. The RayGuard clearly protected the cells from the reduction of cell proliferation and changes in the cell cycle.
This is the first time that the effect of the RayGuard on human cells has been proven in a series of scientific experiments. These results are statistically significant.
Dark Field Microscopy - Heinz Meier
Scientific studies that prove the effectiveness of RayGuard products
Dark field of the experimental therapist Heinz Meier from Oberbühren Switzerland.
In numerous patients in the practice, under the influence of EMF (electromagnetic frequency), clumping of the red blood cells could be detected (so-called roll formation), which receded after the body came into contact with the phone chip, despite further exposure.
Experiment 1 - subjects were taken - after one hour without contact with mobile phone or laptop - blood was drawn. The blood count looks normal . The erythrocytes (red blood cells) are active and in motion.
Experiment 1 - subjects were taken - after one hour without contact with mobile phone or laptop - blood was drawn. The blood count looks normal . The erythrocytes (red blood cells) are active and in motion.
Experiment 2 - Blood was drawn from the test persons after they had telephoned for about 3 minutes with a mobile phone without the RayChip / PhoneChip. The blood count has changed a lot. The erythrocytes have contracted and stuck together to form so-called "rolls of money" . A normal blood flow is no longer guaranteed. Complications arise on the part of the organs, as they can no longer be adequately supplied with blood.
Experiment 3 - The subjects were again blood drawn after they had been talking on the mobile phone with the RayChip / PhoneChip for about 3 minutes. The blood count looks almost normal again . The erythrocytes are no longer stuck together and are moving again
Energy Medical Report - Prognos and Amsat
Dr. med. Manfred Doepp, nuclear medicine specialist
Cell Study
Scientific study with two test series on 10 test persons (randomized with regard to gender and age), including meridian diagnostics (System Prognos®) and segmental diagnostics (System Amsat®), regarding the biological-energetic effects of the RayChip / PhoneChip, compared to a placebo Metal plates of the same size without the RYGuard technology.
Summary of results
The RayChip / PhoneChip investigated bring about an improvement in the energy- medical criteria “energy, functional status and sol-gel status”. The results are statistically significant to highly significant.
When applying the RayChip / PhoneChip to the left palm, there is an increase in energy. When it comes into contact with the so-called thymus point (upper sternum), the informational effects are more pronounced. The skin resistance was measured at defined points on the meridian using the “Prognos or Amsat method”.
Telephone calls with the mobile phone without RayChip / PhoneChip on the ear reduce the organ functions and cause a tendency to apply in the mesenchyme (increase in viscosity in the active connective tissue or the matrix). With the RayChip / PhoneChip on the mobile phone, these biological effects are not only neutralized, but also converted into positive effects that are a little weaker than the negative ones.
LIFE-TEST Institute Ulrich Arndt, Mundingen
LIFE-TEST Institute Ulrich Arnd, Mundingen, Switzerland
Measurements were carried out using the Aschoff test. During a cell phone call, the skin resistance increases significantly (from an average of 50 to 90 kΩ) and then decreases again over the course of several hours after the end of the call. After attaching a Ray Chip to the cell phone, the change was reduced by about 2/3.
Infographic:
Meridian measurements using the Aschoff test, average values from 10 test persons using the Ray-Chip - horizontally measuring point 1-10, vertically the skin resistance in kilo-ohms (kΩ) *.
Blue line: Initial value.
Red line: A heavy load occurs during the mobile phone call.
Green line: During the mobile phone call, but the phone chip compensates for the load by around 67%.
* (The ideal value for a healthy adult is 40 kΩ.
Energy Medical Report - 5G Chip and 5G Pendant
Energy medical report regarding the energetic effects of the products RayGuard "5G Chip" and "5G-Pendant" from Gasser, Hoechst (Austria)
Cell Study
On the following 20 pages I report on a series of tests using the meridian diagnostics (module of the TimeWaver® device), the heart rate variability (TimeWaver Cardio® system), and the aura / chakra diagnostics (module of the TimeWaver® www .timewaver.de), concerning the biological-energetic effects that are caused by the RayGuard “5G Chip” and the “5G Pendant”.
Both produced against technical electrosmog - by the company Gasser, Hoechst (Austria). Both products ( verum ) were compared with placebo products that looked the same .
The test series were carried out by means of randomization and blinding. None of the participating test persons knew what the contents of the devices were. Verum and placebo looked identical.
Summary and certificate of our energy and information tests.
1. Three functional areas of the electrosmog protection devices RayGuard '5G Chip and 5G Pendant' were tested in comparison to placebo: the effects on the vegetative nervous system (heart rate variability to describe stress and the sympathetic and vagal nervous system), on the network of meridians ( "Chi" energy and harmony) and on the chakras (states of energy and coherence). The tests were carried out as randomized, placebo-controlled and blinded test procedures.
2. Both devices are able to balance the autonomous systems of humans , the energy and harmony too.
Improve and strengthen and harmonize the stressed chakras after making a call with a modern smartphone within 2 minutes. With regard to the comparison with placebo situations, the differences are significant, in most tests highly significant.
Dr. med. Dr. med. Manfred Doepp HolisticCenter health center.